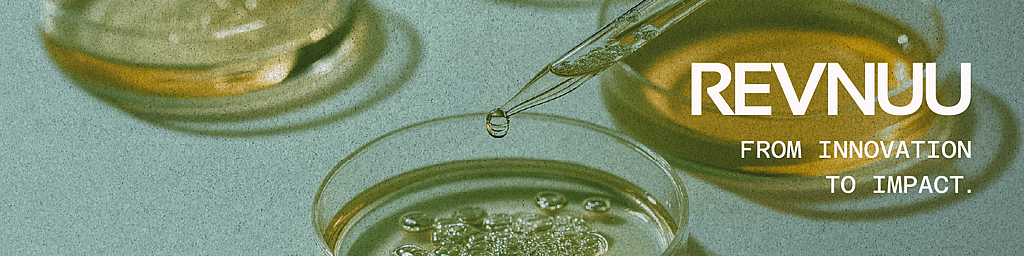
Listing cover image

Revnuu is an award-winning life-sciences and deep-tech marketing partner, delivering strategy and execution that turns pioneering science into market-ready, scalable organisations with lasting positive impact.
- http://revnuu.com
- +41 78 322 96 32
- Send an email
- Tinotenda Chanakira
Some insights
Revnuu empowers science or engineering based companies to make their way to the market to create solutions for a smarter, healthier and sustainable planet.
We work with some of the leading companies globally to help them turn their scientific innovation to companies with positive global impact.
The innovators who put in the work to build solutions and services to make the world a better palce
We have deep technical and scientific knowledge to propel deep-tech companies to be come global competitors. We have have a unique know and have won awards which speak testament to our dedication to the craft of seeing innovative companies make it to market.
Work in Marketing and Communications for deep-tech companies.
By integrating us into their ecosystem.